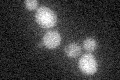
YFR022W
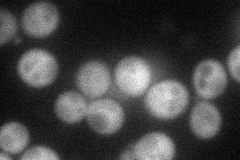
YFR022W
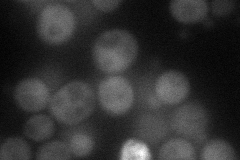
YFR022W
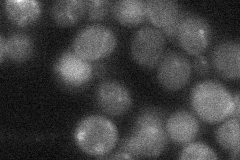
YFR022W

View description
Protein that binds the ubiquitin ligase Rsp5p via its 2 PY motifs; has similarity to Rod1p; mutation suppresses the temperature sensitivity of an mck1 rim11 double mutant; proposed to regulate the endocytosis of plasma membrane proteins
Localization:
Intensity:
Fold change:
Significance:
-
C’ GFP library in SD
below threshold17.34 -
N' NOP1pr-GFP in SD
cytosol45.6019 -
N' TEF2pr-mCherry in SD
cytosol45.2292 -
N' NATIVEpr-GFP in SD
below threshold19.7576 -
N' TEF2pr-VC and Cyto-VN in SD

cytosol30.4338 -
C’ GFP library in SD+DTT

cytosol16.460.94No -
C’ GFP library in SD+H2O2

cytosol18.341.05No -
C’ GFP library in Starvation Media

cytosol16.20.93No -
C’ GFP library on the background of Pup2-DaMP

below threshold -
C’ GFP library on the background of CCT mutant

below threshold18.05751.04086No
